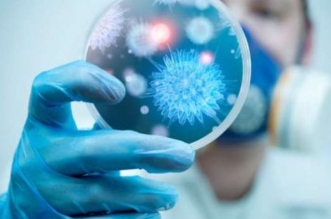

أعلنت وزارة الصحة في حكومة الانقلاب عن تسجيل 755 حالة إصابة جديدة بفيروس كورونا و39 حالة وفاة وارتفاع حالات الشفاء . فيما قال الدكتور مصطفى جاويش، المسئول السابق في ...
أقرأ المزيد
التعليقات على خبراء: عزوف المواطنين عن تلقي لقاح كورونا بسبب تخبط صحة الانقلاب مغلقة
أخبار
رغم فشل نظام الانقلاب العسكري في مواجهة جائحة فيروس كورونا المستجد وعجزه عن تقديم العلاج والرعاية للمصابين بسبب انهيار المنظومة الصحية إلا أنه لا يكتفى بذلك بل يحمل ...
أقرأ المزيد
التعليقات على نهب متعلقات مرضى كورونا بمستشفيات العزل.. فضيحة جديدة لوزارة الصحة مغلقة
وكأنّ المصائب لا تأتي منفردة على مصر في ظل حكم العسكر، الذين لا يجيدون إلا "تمام يا أفندم" والكفر بدراسات الجدوى، وإنهاء القرارات الإستراتيجية في ثانية بين كامل ...
أقرأ المزيد
التعليقات على خلال 3 سنوات.. روسيا تطرح مسارا بديلا يهدد قناة السويس مغلقة
في صورة تعكس حجم السفه والفساد المستشري في أوصال الدولة المصرية، يتقاضى الدكتور علي عبدالعال رئيس مجلس نواب الانقلاب السابق والعضو المعين بالمجلس الحالي على كافة مستحقاته رغم ...
أقرأ المزيد
التعليقات على منتهى السفه والفساد.. “عبدالعال” يتقاضى 75 ألف جنيه شهريا بدون عمل و”الكتاتني” بالسجن دون تهمة! مغلقة
قال الدكتور مصطفى شاهين أستاذ الاقتصاد بجامعة أوكلاند الأمريكية، إن الصكوك السيادية تعد حديثة نسبيا في مجال الاقتصاد، مضيفا أن السندات هي صك مديونية تكون مدينة به الشركة ...
أقرأ المزيد
التعليقات على خبير اقتصادي: الصكوك السيادية تفتح الباب لبيع مقدرات مصر مغلقة
نشرت صحيفة "الجارديان" البريطانية تقريرا سلطت خلاله الضوء على الانتقادات التي وجهها عدد من النشطاء الأمريكيين للرئيس الأمريكي جو بايدن بسبب تجاهل "تكتيكات احتجاز الرهائن" التي يتبعها نظام ...
أقرأ المزيد
التعليقات على “الجارديان”: انتقادات حقوقية لبايدن بسبب تغاضيه عن جرائم السيسي مغلقة
تواصل سلطات الانقلاب عزف سيمفونية القمع المتواصل للمصريين مستخدمة البرلمان الذي اختارته الأجهزة الأمنية المستبدة بالوطن والمواطنين حيث أقرت "اللجنة التشريعية" بالمجلس قانونا يقضي بفصل الموظفين الذين ينتمون ...
أقرأ المزيد
التعليقات على قانون فصل الإخوان.. عصا السيسي لتصفية العاملين بالجهاز الإداري للدولة مغلقة
يواصل نظام الانقلاب إغراق مصر في مستنقع الديون وتضييع مستقبل الأجيال الحالية والمقبلة مع رهن سيادة البلاد وقرارها السياسي للدائنين الأجانب وهو ما قد يؤدي إلى إعلان إفلاس البلاد وما ...
أقرأ المزيد
التعليقات على 150 مليار دولار ديون خارجية نهاية 2021.. السيسي يقود مصر للإفلاس مغلقة
أكاذيب الانقلاب لا تتوقف والإنجازات الوهمية تتدفق كل يوم على روؤس المصريين، فكل يوم يزعم نظام الانقلاب أنه حقق إنجازات غير مسبوقة لم تشهدها مصر من قبل، وأن ...
أقرأ المزيد
التعليقات على بعد إعلان البنك المركزي.. خبراء: ارتفاع الاحتياطي الأجنبي “غش وتدليس” مغلقة
بعد أيام من اعتقال 30 متظاهرا بعزبة نادي الصيد بالإسكندرية، بينهم أطفال لمنع خروج الأهالي في مظاهرات جديدة ضد قرار تهجيرهم قسريا، اعتقلت داخلية الانقلاب بالإسماعيلية الاثنين 7 ...
أقرأ المزيد
التعليقات على اعتقل الأطفال والطلاب وأحرق القاصرات.. امتهان حقوق المصريين من ركائز “جمهورية السيسي الجديدة”! مغلقة